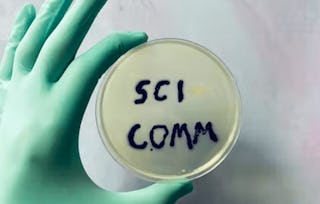

This course presents strategies for scientists to use when engaging a variety of audiences with scientific information. Students will learn to communicate their knowledge through both textual and visual strategies, as well as practice document preparation using appropriate formatting, style, and graphics. Written assignments, discussion questions, and communication exercises will provide students with a better understanding of the relationship between scientists and diverse audiences, whether in the workplace, laboratory, or other environments.

Communicating Science

Recommended experience
Recommended experience
Details to know

Add to your LinkedIn profile
36 assignments
See how employees at top companies are mastering in-demand skills

There are 9 modules in this course
Welcome to Public Engagement for Scientists! Module 1 delves into the multifaceted role of scientists in society, highlighting the challenges and responsibilities in communicating scientific knowledge. It aims to equip students with a nuanced understanding of what constitutes scientific expertise, the interplay between science and the public sphere, and the inherent communication challenges faced by scientists today.
What's included
8 videos6 readings4 assignments1 discussion prompt
8 videos•Total 48 minutes
- Course Overview•3 minutes
- Instructor Introduction•1 minute
- Module 1 Introduction - Scientific Mistrust Through History•7 minutes
- Knowledge Production as a Social Process•7 minutes
- Who is an Expert Today? Who Makes Knowledge?•8 minutes
- Science and the Public Sphere •8 minutes
- Key Challenges When Communicating Science•7 minutes
- Key Challenges When Communicating Science - Part 2•6 minutes
6 readings•Total 250 minutes
- Syllabus•10 minutes
- Module 1 Introduction•60 minutes
- What is a Scientist Expert?•90 minutes
- Public Sphere Theory •20 minutes
- Key Communication Challenges•60 minutes
- Module 1 Summary•10 minutes
4 assignments•Total 165 minutes
- What is a Scientific Expert Quiz•15 minutes
- Science and the Public Sphere Quiz•15 minutes
- Key Communication Challenges Quiz•15 minutes
- Module 1 Summative Assessment•120 minutes
1 discussion prompt•Total 10 minutes
- Meet and Greet Discussion•10 minutes
This module is designed to enhance students' skills in tailoring written communication effectively for diverse audiences and purposes. It focuses on the art of revising and editing texts to match the audience's vocabulary level, ensuring conciseness and precision, and utilizing visual elements like typesetting and color for enhanced comprehension. The course combines theoretical knowledge with practical exercises, enabling students to master the intricacies of impactful written communication.
What's included
6 videos4 readings5 assignments
6 videos•Total 44 minutes
- Module 2 Introduction - “This text is too dense!” •5 minutes
- How to Scale Vocabulary•9 minutes
- How to Scale Detail•7 minutes
- How to Edit for Concision and Precision•8 minutes
- Document Design for Comprehension•8 minutes
- Color, Typesetting, etc.•7 minutes
4 readings•Total 180 minutes
- Scaling Vocabulary and Detail•20 minutes
- Concision & Precision•105 minutes
- Document Design•45 minutes
- Module 2 Summary•10 minutes
5 assignments•Total 180 minutes
- Practice sorting texts by what audience they would be appropriate for•15 minutes
- Scaling Vocabulary and Detail Quiz•15 minutes
- Concision and Precision Quiz•15 minutes
- Document Design Quiz•15 minutes
- Module 2 Summative Assessment•120 minutes
This module dives into the skills required for effective data management and visualization. It focuses on the foundational techniques of cleaning and structuring both quantitative and qualitative data, understanding and selecting appropriate types of data visualizations for different rhetorical purposes, and crafting meaningful captions, legends, titles, and labels to enhance the interpretability and impact of data presentations.
What's included
7 videos6 readings4 assignments1 ungraded lab
7 videos•Total 48 minutes
- Module 3 Introduction - Why Data Visualization is Hard, and Rhetorical •6 minutes
- How Should I Organize this Data? •8 minutes
- Cleaning and Organizing Data in R•5 minutes
- Choosing the Right Data Visualization Form •10 minutes
- Creating different types of Data Visualization in R•6 minutes
- Captions, Legends, Labels•7 minutes
- Making Captions, Legends, and Labels in R•5 minutes
6 readings•Total 125 minutes
- How Charts Lie•20 minutes
- Cleaning Data & Pitfalls•60 minutes
- How Data Visualizations Tell a Story•10 minutes
- How to Write a Good Caption Reading•15 minutes
- Module 3 Summary•10 minutes
- Insights from an Industry Leader: Learn More About Our Program•10 minutes
4 assignments•Total 165 minutes
- Cleaning and Organizing Raw Data Quiz•15 minutes
- Data Visualization Quiz•15 minutes
- Captions, Legends, Titles, and Labels Quiz•15 minutes
- Module 3 Summative Assessment•120 minutes
1 ungraded lab•Total 60 minutes
- R Studio Lab: Creating Data Visualizations from Raw Data•60 minutes
This module is designed to provide students with an in-depth understanding of the interplay between human visual perception and data visualization, alongside the ethical considerations inherent in the field. It covers the psychological and physiological aspects of how the human eye processes visual information, particularly in the context of data presentation. Additionally, the module delves into the ethical dimensions of data visualization, highlighting potential pitfalls and the responsibilities of data communicators in representing information truthfully and responsibly. Students will learn to critically analyze visual data presentations, both in terms of how effectively they convey information and their adherence to ethical standards.
What's included
7 videos4 readings3 assignments
7 videos•Total 49 minutes
- Module 4 Introduction•5 minutes
- Less is More: Helping Humans to Focus on the Right Thing in Your Data Visualization•10 minutes
- Using Color Strategically with Data•8 minutes
- Accessibility and Data Visualization•7 minutes
- A Brief History Lesson: Ethically Murky Waters in Data Visualization•7 minutes
- Ethical Framework for Data Visualization - Part 1•5 minutes
- Ethical Framework for Data Visualization - Part 2•7 minutes
4 readings•Total 125 minutes
- Demonstrating Misleading Data Visualizations •30 minutes
- How Humans Read Data Visualizations•25 minutes
- Ethical Guidelines•60 minutes
- Module 4 Summary•10 minutes
3 assignments•Total 150 minutes
- How Humans Read Data Visualizations Quiz•15 minutes
- Ethics and Data Visualizations Quiz•15 minutes
- Module 4 Summative Assessment•120 minutes
This module is tailored to provide students with a comprehensive understanding of the objectives and expectations within the research community. It aims to demystify the purposes and methodologies behind key forms of scientific communication, namely research papers and technical reports. Students will explore the goals driving academic research, delve into the structure and function of research papers, and understand how these papers serve as critical tools for communicating complex information. The module also covers technical reports, explaining their purpose, structure, and how they differ from research papers in conveying detailed information. Through this module, students will develop a clearer perspective on the nuances of scientific communication and its role in advancing knowledge in the research community.
What's included
10 videos5 readings4 assignments
10 videos•Total 66 minutes
- Module 5 Introduction - What Kinds of Writing Do Researchers Read and Why?•5 minutes
- Goals and Expectations of the Research Community - Part 1•6 minutes
- Goals and Expectations of the Research Community - Part 2•7 minutes
- What is the Purpose of a Research Paper? And How Do I Read One? - Part 1•9 minutes
- What is the Purpose of a Research Paper? And How Do I Read One? - Part 2•9 minutes
- How Scientific Information is Communicated in a Research Paper - Part 1•6 minutes
- How Scientific Information is Communicated in a Research Paper - Part 2•5 minutes
- How are Technical Reports Different Than Research Papers? •8 minutes
- How to Write Massive Amounts of Technical Detail, Accurately - Part 1•6 minutes
- How to Write Massive Amounts of Technical Detail, Accurately - Part 2•5 minutes
5 readings•Total 245 minutes
- Academic Writing•25 minutes
- What is Research?•60 minutes
- Sample Data-Driven Research Papers•90 minutes
- Sample Data-Driven Technical Reports•60 minutes
- Module 5 Summary•10 minutes
4 assignments•Total 165 minutes
- Who are Researchers Quiz•15 minutes
- Research Papers Quiz•15 minutes
- Technical Reports Quiz•15 minutes
- Module 5 Summative Assessment•120 minutes
This module focuses on the critical aspects of communication within a professional scientific setting. It is designed to equip students with the skills necessary to communicate effectively with peers, emphasizing the importance of concision and precision in delivering clear and impactful messages. The module delves into the key rhetorical features of internal documentation, illustrating how to effectively convey complex information in a manner that is easily comprehensible to team members. Additionally, students will learn the art of crafting effective messages for peer-to-peer communication, a vital skill for successful collaboration and project management.
What's included
8 videos5 readings6 assignments
8 videos•Total 54 minutes
- Module 6 Introduction - Expert to Expert Communication is Still Hard•3 minutes
- Principle 1: Bottom-line-up-front (BLUF)•10 minutes
- Principle 2: Concision and Precision - Part 1•5 minutes
- Principle 2: Concision and Precision - Part 2•7 minutes
- Types of Internal Documentation•5 minutes
- Key Rhetorical Moves in Internal Documentation•9 minutes
- How to Write a Good Memo•8 minutes
- Types of Professional Writing•6 minutes
5 readings•Total 150 minutes
- Importance of Good Peer Communication•30 minutes
- BLUF •30 minutes
- Internal Documentation•45 minutes
- Professional Writing (emails, memos, chat messages, etc.)•35 minutes
- Module 6 Summary•10 minutes
6 assignments•Total 195 minutes
- BLUF Practice Activity•15 minutes
- BLUF Quiz•15 minutes
- Internal Documentation Quiz•15 minutes
- Professional Writing Practice Activity•15 minutes
- Professional Writing Quiz•15 minutes
- Module 6 Summative Assessment•120 minutes
This module is crafted to enhance students' understanding and skills in tailoring communication effectively based on audience needs. It emphasizes the strategic selection and reframing of information to ensure clarity, relevance, and engagement for various audiences. Students will learn how to identify and analyze the specific needs and expectations of their audience, guiding their decisions on what information to include and how to present it. The module also covers techniques for adjusting the complexity of communication, known as editing up or down, to suit the audience's level of understanding and interest.
What's included
8 videos5 readings4 assignments
8 videos•Total 57 minutes
- Module 7 Introduction - Genre Variation in Communicating Science to Other Professionals•2 minutes
- Audience Theory & Reader-Based Prose•7 minutes
- Deciding What Information Your Audience Needs•8 minutes
- Frame Theory •8 minutes
- Picking the Right Frame•9 minutes
- What Will My Audience Be Able to Understand?•10 minutes
- Editing for the “Hard Stuff” - Part 1•6 minutes
- Editing for the “Hard Stuff” - Part 2•8 minutes
5 readings•Total 110 minutes
- Case Study in Difficulty Communicating Across Professions•30 minutes
- Case Study in Choosing Information Strategically•30 minutes
- Case Study in Reframing Information •30 minutes
- Case Study in Editing Information for Complexity•10 minutes
- Module 7 Summary•10 minutes
4 assignments•Total 165 minutes
- Choosing Information Strategically Quiz•15 minutes
- Reframing Information Quiz•15 minutes
- Editing Information Quiz•15 minutes
- Module 7 Summative Assessment•120 minutes
This module is designed to equip students with a comprehensive understanding of the multiple factors that influence public opinion and the essentials of constructing a persuasive public argument. It begins by exploring the various elements that shape public opinion, including cultural, social, political, and psychological factors. Students will then delve into the fundamentals of building a strong public argument, learning how to develop a logical structure, use rhetorical techniques, and engage the audience effectively. A key focus of the module is on the strategic use of data in supporting arguments, teaching students how to integrate statistical evidence to enhance persuasiveness and credibility. Additionally, the course examines the impact of document design on argument presentation, including the use of layout, typography, and visual elements to reinforce the message and facilitate comprehension.
What's included
9 videos6 readings5 assignments
9 videos•Total 63 minutes
- Module 8 Introduction - Quick review of Module 1 and How We'll Use Foundations in this Module•2 minutes
- Why the Public Doesn't Always Believe the Data •10 minutes
- Why the Public Doesn't Always Believe Experts - Part 2•10 minutes
- Argument Theory - Part 1•7 minutes
- Argument Theory - Part 2•5 minutes
- Elements of a Strong Scientific Argument •8 minutes
- How to Use Data as Part of Your Argument•7 minutes
- Case Studies on (In)Effective Data Usage•6 minutes
- Principles in Effective Data Design for Public Arguments•7 minutes
6 readings•Total 230 minutes
- Public Data Communication Pitfalls•10 minutes
- How the Public Forms Opinions•45 minutes
- Argument Structure •60 minutes
- Public-Facing Data Visualizations•60 minutes
- Document Design and Color for the Public•45 minutes
- Module 8 Summary•10 minutes
5 assignments•Total 180 minutes
- Why Expertise and Data Are Not Enough Quiz•15 minutes
- Argument Structure Quiz•15 minutes
- Public-Facing Data Visualizations Quiz•15 minutes
- Document Design, Color, and Typesetting Quiz•15 minutes
- Module 8 Summative Assessment•120 minutes
This module contains the summative course assessment that has been designed to evaluate your understanding of the course material and assess your ability to apply the knowledge you have acquired throughout the course.
What's included
1 assignment
1 assignment•Total 180 minutes
- Summative Course Assessment•180 minutes
Build toward a degree
This course is part of the following degree program(s) offered by Illinois Tech. If you are admitted and enroll, your completed coursework may count toward your degree learning and your progress can transfer with you.¹
Instructor

Offered by
Why people choose Coursera for their career

Felipe M.

Jennifer J.

Larry W.

Chaitanya A.
Explore more from Data Science
 U
UUniversity of Colorado Boulder
Course
 U
UUniversity of Colorado Boulder
Course
U
UUniversity of Colorado Boulder
Specialization
 E
EErasmus University Rotterdam
Course
